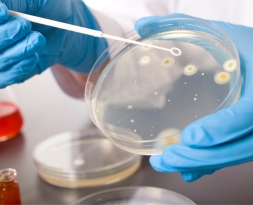
Petri dist test

Precision. Quality.
Innovation.
We Care For Your Research Needs
Supporting laboratories worldwide with reliable plasticware and equipment.
10,000+
Happy Customers
Why Choose Moxcare
Elevate Your Lab Standards With Moxcare!
Our Certificate
SUPPORTING GLOBAL SCIENTIFIC PROGRESS
Industries We Proudly Serve
At Moxcare Labwares, our high-quality products and equipment support diverse industries and research fields worldwide. We’re proud to be a trusted partner to organizations that rely on accuracy, safety, and innovation in every experiment.
-
1
Contract Research Organizations (CROs)
We supply precision labware and instruments that meet global standards -ensuring reproducibility and reliability for advanced contract research projects. -
2
Pharmaceutical Manufacturing
From production to quality control, our labware and accessories support pharmaceutical labs with sterile, durable, and compliant solutions. -
3
Food and Beverage Quality Control
Our specialized testing tools and filtration products help maintain safety and purity standards in food and beverage testing environments. -
4
Government and Educational Research Labs
Trusted by national institutes and universities, Moxcare products empower scientific learning and innovation at every level.

Trusted by 1 Million + users around the world






























Client Experiences
Join Our Happy
Trusted Lab Reviews
Moxcare pipette tips were recommended by another lab, and after using them for several months, we’re very satisfied. They fit perfectly, dispense smoothly, and deliver consistent results. Highly recommended for routine lab work.
Mr. Rohit
Senior Lab Technician
We have been using Moxcare products regularly in our laboratory and have not faced any issues so far. The quality has been consistent and reliable.
Dr. Prerna
Research Associate
I had a minor issue, and the customer support team resolved it quickly. I really appreciate their prompt response and follow-up.
Ms. Archita Jain
Quality Control Executive
Excellent quality labware products and outstanding customer support. Very happy with the service.
Mr. Tushar
Lab Operations Head
A reliable company with a very supportive and responsive team.
Mr. Guru
Procurement Manager
Our Products
Explore Moxcare’s comprehensive range of laboratory products designed to support research precision, efficiency, and safety. From essential plasticware to advanced benchtop instruments, every product reflects our commitment to international quality and innovation.


EMPOWERING RESEARCH
Transform Laboratories Through Innovation
Moxcare Labwares delivers high-quality, ISO-certified laboratory plasticware and benchtop equipment designed to support global scientific progress with precision, durability, and trust.
Our Featured Products
Featured Video
Product Catalogue
Explore the complete range of Moxcare Labwares plasticware and benchtop equipment in our latest product catalogue. Find detailed specifications, sizes, and ordering information to help you choose the right solutions for every laboratory application.

Blog & Insights
Latest news and insights from industry
It seems we can't find what you're looking for.


Common Questions
Frequently Asked Questions
At Moxcare Labwares, we’re here to help you with questions about our lab products, customization, and global delivery.
What products does Moxcare Labwares manufacture?
We offer labware, PCR products, cell culture items, filtration products, reusable labware, nitrile gloves, racks & boxes, autosampler vials, lab accessories, and benchtop instruments
Are your products ISO certified?
Yes, our products are manufactured under ISO 13485:2003 and meet international laboratory standards.
Do you export globally?
Yes, we supply laboratories and industries worldwide through our global distribution network.
Which industries do you serve?
We serve CROs, pharmaceutical manufacturers, food and beverage testing labs, government institutes, and educational and research laboratories.
Do you offer reusable or eco‑friendly labware?
Yes, we provide durable, autoclavable reusable labware designed for long-term use and cost efficiency.
Can I request custom product specifications or OEM branding?
Yes, many products can be customized in size, color, packaging, or private‑label branding—contact us with your requirements.
How can I place an order or get a quote?
You can order through our trusted resellers or contact us directly via the website, email, or phone for a quotation
Where can I download your product catalogue and certificates?
Our catalogues, brochures, and certificates are available in the Download / Product Catalogue section of the website.
How can I become a Moxcare distributor or reseller?
Simply reach out via the Contact Us page with your company details and location, and our team will get in touch.